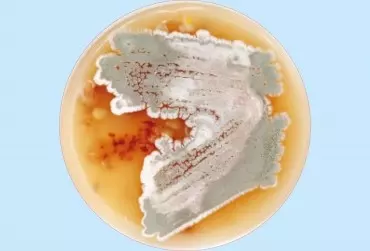

Autor: Dr Beata Kowalska
Termin „mykotoksyny” pochodzi od słów: greckiego mycos – grzyb oraz łacińskiego toxicum – trucizna. Mykotoksynami określa się toksyczne substancje chemiczne wytwarzane przez pewne gatunki grzybów pleśniowych rozwijających się m.in. na produktach żywnościowych i surowcach wykorzystywanych do ich produkcji.
Bakterie fermentacji mlekowej są Gram-dodatnimi niesporującymi ziarenkowcami, pałeczkami lub laseczkami. Przeprowadzają fermentację glukozy do kwasu mlekowego, etanolu i CO2. Wszystkie bakterie mlekowe są beztlenowcami, niektóre z nich tolerują niewielkie stężenie tlenu w środowisku.
Bakterie symbiotyczne roślin motylkowatych bytują w glebie jako saprotrofy, a liczebność ich populacji w środowisku glebowym zależy zarówno od czynników glebowo-klimatycznych, jak i od zabiegów agrotechnicznych.
Szacuje się, że w 1 g piasku pustynnego znajduje się od 1 x 103 do 1 x 106 kolonii promieniowców, podczas gdy w 1 g gleby znajduje się 1 x 107 tych kolonii.
Gleba należy do najważniejszych i zarazem najbardziej skomplikowanych środowisk naturalnych, w których rozwijają się drobnoustroje. Glebę zasiedla ogromna liczba drobnoustrojów, które stanowią 0,2% jej ciężaru i zajmują 1,33% jej objętości.
Bakterie z rodzaju Pseudomonas są najbardziej różnorodną i znaczącą ekologicznie grupą bakterii na naszej planecie. Szczepy tego rodzaju występują licznie we wszystkich naturalnych środowiskach: lądowym i wodnym.